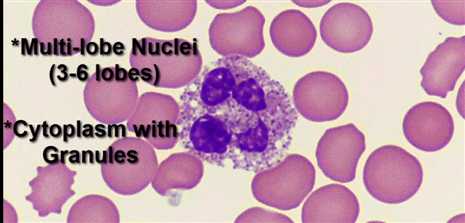
bubuko.com,布布扣

成年人血液中中性粒细胞的数量约占白细胞总数的55%一70%
中性粒细胞在杀死吞噬的细菌等异物后,本身也死亡,死亡的中性粒细胞称为脓细胞。
中性粒细胞的吞噬能力很强,与单核/巨噬细胞一起统称为吞噬细胞.
感染发生时中性粒细胞首先到达炎症部位,6h左右数量可达高峰,约增加10倍以上。中性粒细胞识别和吞噬病原体的过程与单核/巨噬细胞相似,所不同的是,中性粒细胞对病原体的杀伤是通过其胞质颗粒中的酶来完成的
neutrophil有3-6个核,属于颗粒细胞
原文:http://www.cnblogs.com/biopy/p/4072878.html